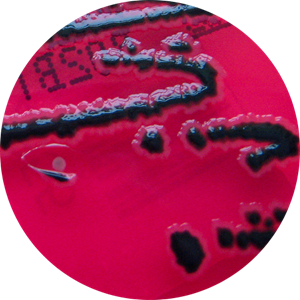

Caso clínico – qual sua hipótese diagnóstica? #2 [atualizado]
Antes de continuar a leitura do texto, quero te convidar para conhecer meus cursos:
- Hematologia básica clique aqui
- Anemias clique aqui
- Onco-hematologia clique aqui
- Interpretando o hemograma clique aqui
- Curso de Hematologia (10% off) clique aqui
- Preparatório de Análises Clínicas para Residência e Concurso clique aqui
Continue agora com a sua leitura do texto. Espero que goste.

(atualizado em 25/10/14) Resposta: Foram 569 respostas e 72% dos participantes acertaram. A resposta certa é Salmonella typhimurium. Clique aqui para ver a explicação.

Homem de 27 anos foi a um casamento e comeu churrasco, sushi, maionese e sorvete. No dia seguinte, o mesmo acordou com diarreia intensa não sanguinolenta. Foi ao médico, realizou-se exame de coprocultura e os resultados estão apresentados abaixo.

Coloração de Gram

Ágar XLD Ágar Sangue


Ágar MacConkey Ágar TSI
Motilidade – Positivo / H2S – Positivo / Catalase – Positivo / Oxidase – Negativo
Caso não esteja visualizando a enquete, clique aqui
Caso clínico desenvolvido por:
Dennis Leandro, 6° Semestre - Faculdade Metrocamp
Victor Borin, 6° Semestre - UNIP
Campinas - SP







